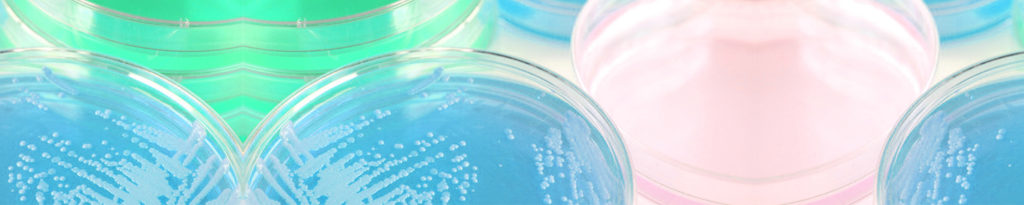

Master your microbial issues in the paper industry
As a significant water consumer, the paper industry has adapted by reusing its industrial water.…
Célia Martinez18 July 2023